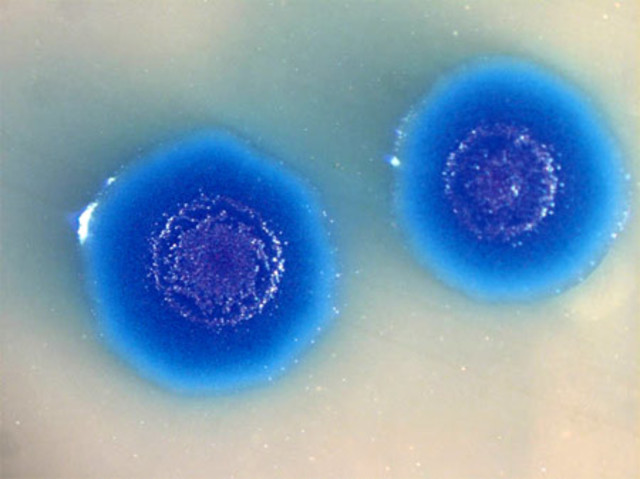
primera célula sintética capaz de autoreplicarse

-
Gegor Mendel publica sus experimentos con plantas
híbridas, y llama a los resultados de su investigación “Leyes
de la herencia”, por lo que se le considera el padre de la
genética. las “unidades hereditarias” (genes) no se mezclan sino que se transmiten con toda la información, y uno de los factores
resulta dominante sobre el otro (recesivo), lo que da origen
a la formulación de las leyes fundamentales de la herencia. -
Friedrich Miescher aisló los núcleos a partir de células presentes en pus de vendajes quirúrgicos, y comprobó que los núcleos contenían una
sustancia química homogénea y no proteica a la que denominó
nucleína -
Richard Altman acuñó el termino de ácidos nucleicos para la nucleína
-
Albretch Kossel demostró que la nucleína de Miescher
contenía proteínas y moléculas básicas ricas en nitrógeno,
lo que llevó a la identifi cación de lo que hoy se conoce
como bases nitrogenadas. -
La teoría dice que los genes individuales se encuentran en lugares específicos en cromosomas particulares y que el comportamiento de los cromosomas durante la meiosis puede explicar por qué los genes se heredan de acuerdo a las leyes de Mendel.
-
Thomas Hunt Morgan realizó unos experimentos hoy considerados
clásicos sobre los rasgos genéticos ligados al sexo. Sus contribuciones científicas más importantes se centraron en el
campo de la genética, y demostró que los cromosomas son portadores de los genes, lo que dio lugar a lo que se conoce
como la teoría cromosómica de Sutton y Boveri. -
Calvin Bridges demostró que los genes están en los
cromosomas -
Alfred Henry Sturtevant demostró que algunos genes
tienden a heredarse juntos y dedujo que se localizan en el
mismo cromosoma. -
se publicó el libro El mecanismo de la herencia mendeliana escrito por Thomas H. Morgan, Alfred Sturtevant, Hermann Muller y Calvin Bridges,en el que se establecían de forma definitiva las bases fundamentales de la herencia genotípica, se iniciaba la teoría cromosómica de la herencia y se consolidaba la edad de oro de la genética clásica.
-
Frederick Griffith descubrió el “principio transformante”, que hoy se conoce como ADN
-
al realizar estudios de difracción por rayos X, propusieron que el ADN era una fibra compuesta de bases nitrogenadas apiladas a
0.33 nm unas de otras. Además, fue
el primer científico en autodenominarse biólogo molecular. -
George Wells Beadle y Edward Lawrie Tatum encontraron sólidas evidencias de una correlación entre los genes y las enzimas que proponían un vínculo directo entre ellos, conocido como la hipótesis “Un gen, una enzima”.
-
El médico italiano Salvador E. Luria, conocido por
el medio de cultivo para E. coli LB (Luria broth), y Max Delbrück
demostraron que las mutaciones en E. coli ocurrían
de forma espontánea, sin necesidad de exposición a agentes
mutagénicos, y que éstas se transmitían siguiendo las leyes de
la herencia. -
Avery, MacLeod y McCarty demostraron
que las cepas inocuas de neumococo estudiadas por
Griffith se transformaban en patógenas al adquirir la molécula
de ADN y no proteínas, como se creyó en un principio,
y demostraron así que el principio transformante era ADN -
Erwin Chargaff descubre las leyes que rigen la complementariedad de bases de los ácidos nucleicos. Mediante cromatografía en papel, Chargaff demostró que el ADN aislado de diferentes organismos
contiene la misma proporción de Adeninas y de Timinas,
así como de citosinas y de guaninas. -
Alfred Hershey y Martha Chase, utilizando bacteriófagos marcados con isótopos radiactivos 35S o 32P, demostraron que cuando un virus infecta a una bacteria solamente penetra el ADN viral.
-
La quimicofísica Rosalind Elsie Franklin, mediante estudios
de difracción de rayos X, descubrió que el ADN presentaba
los grupos fosfato hacia el exterior y podía hallarse de dos
formas helicoidales distintas: las que hoy conocemos como
ADN-A y ADN-B -
el bioquímico estadounidense Watson y el biofísico
inglés Crick, elaboraron el famoso modelo
de la doble hélice de ADN, que explicaba de manera clara
que el ADN podía duplicarse y transmitirse de una célula a
otra. -
Mathew Stanley Meselson y Franklin Stahl confirmaron la replicación semiconservadora. En su experimento utilizaron centrifugación con gradientes de soluciones de cloruro de cesio (CsCl).
-
Hamilton Smith, descubrió que las bacterias
infectadas por virus liberaban unas enzimas (enzimas de
restricción), que los inactivan al cortar sus secuencias
de ADN -
Steward Lynn y Werner Arber descubrieron
los sistemas de restricción de las bacterias.Las enzimas de restricción son enzimas que reconocen y cortan las moléculas de DNA por secuencias nucleotídicas específicas. -
se aísla la primera enzima de restricción Hind II, a partir de Haemophilus influenzae
-
Howard Martin Temin y David Baltimore, de manera independiente
descubrieron una nueva enzima denominada transcriptasa
inversa o retrotranscriptasa, con función de ADN polimerasa
dependiente de ARN -
Kary Banks Mullis desarrolló una técnica innovadora
que revolucionó la investigación en biología molecular:
la reacción en cadena de la polimerasa. La reacción en cadena de la polimerasa (PCR) es una técnica de laboratorio común utilizada para hacer muchas copias de una región particular de ADN. Esta región de ADN puede ser cualquier cosa que le interese al experimentador. -
Fue un proyecto internacional de investigación científica con el objetivo fundamental de determinar la secuencia de pares de bases que componen el ADN e identificar los aproximadamente 30 000
genes del genoma humano, desde un punto de vista físico y
funcional. -
Dolly, fue el primer mamífero clonado a partir de una célula
adulta. Sus creadores fueron Ian Wilmut y Keith Campbell. Dolly
fue una oveja resultado de una transferencia nuclear desde
una célula donante diferenciada (de glándula mamaria) a un
óvulo no fecundado y anucleado. Cinco meses después nacía
Dolly, la única cría resultante de 277 fusiones de óvulos anucleados
con núcleos de células mamarias. -
-
Las conclusiones
obtenidas al fi nalizar este proyecto fueron las siguientes:
• El genoma humano está constituido por 3000 millones
de pares de bases.
• Existen 25000 genes codifi cantes.
• La homología en la secuencia de ADN entre individuos
es del 99.99%.
• La especie más cercana fi logenéticamente al ser humano
es el chimpancé, con 99.9% de homología en su
secuencia de ADN -
Genetistas japonenses encabezados por el profesor shinya yamanaka, obtuvieron células madre a partir de células de piel humana. Con ayuda de un virus, los investigadores integraron en el ADN de la piel las proteínas que regulan la actividad de los genes y determinan el cambio del tipo de célula.
-
El Craig Venter Institute ha sintetizado el genoma completo de una bacteria, lo que supone la segunda etapa de las tres necesarias para crear un organismo vivo artificial.
-
Craig venter y su equipo han logrado fabricar en el laboratorio el ADN completo de la bacteria 'Mycoplasma mycoides' e introducirlo en otra célula recipiente de otra especie llamada 'Mycoplasma capricolum'.
-
Bruce A. Beutler y Jules A. Hoffmann descubrieron los TLRs que permiten el desarrollo innato de inmunidad hacia ciertas infecciones. Ralph M. Steinman por otro lado, descubrió y caracterizó las células dendríticas del sistema inmune, las cuales se ubican en la periferia de ciertos tejidos en donde puedan entrar patógenos para su detección temprana.
-
Identificaron el mecanismo por el cual las vesículas pueden moverse hacia áreas específicas de la célula y fusionarse con los organelos y la membrana plasmática. Se identificaron tres genes esenciales para la formación y transporte de vesículas, además de ciertas proteínas necesarias para la fusión de las vesículas con la membrana plasmática.
-
Meselson M, Stahl F.W. Th e replication of DNA in Escherichia coli.
Proc Natl Acad Sci, 1958;44:671-682.
Mullis K.B. Reacción en cadena de la polimerasa. Investigación y
Ciencia. 1990;165:30-37.
Venter J.C., Adams M.D., Myer E.W,. et al. Th e sequence of the
human genome. Science, 2001;291:1304-1351.
Watson J.D. Biología Molecular del gen, 5ª ed. Madrid: Médica Panamericana,
2006:7-46.
Watson J.D, Crick F.H.C. A structure for deoxyribose nucleics acids.
Nature, 1953;171:737-738. -
Griffi th F. Th e signifi cance of pneumococcal types. J Hyg,
1928;27:113-159.
Karp G. Biología celular y molecular, conceptos y experimentos, 4ª ed.
México, DF: McGraw-Hill, 2006.
Luque J., Herráez A. Texto ilustrado de Biología Molecular e Ingeniería
Genética, 1ª ed. Madrid: Elsevier, 2001.
www.nobelprize.org
Looking for a timeline maker?
Create timelines for projects, roadmaps, history, lessons, legal cases, and stories with Timetoast. Timetoast is a timeline maker for work, school, research, and stories.